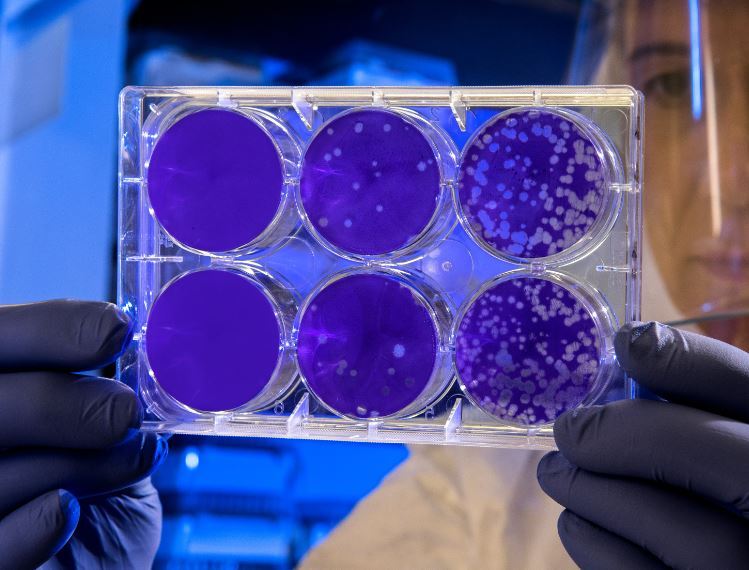

У англичанки случился психический криз после неспецифичного решения маркетологов представить рекламу на сенсорном экране холодильника.
У англичанки случился психический криз после неспецифичного решения маркетологов представить рекламу на сенсорном экране холодильника.
В Госдуме предупредили граждан: обязательный масочным режим может вернуться в Россию
Россиян предупредили о том, что масочный режим может вернуться в страну при определённых ...
Можно ли хранить детскую коляску в подъезде.
Вопрос ответ портала Пензаинформ https://www.penzainform.ru/questions/communal/mozhno_li_hranit_kolyaski_v_holle_podezda_50d6.
Доверься псевдоспециалисту по подбору дорогой иномарки и лишись как денег, так и не получи авто. Мошенническая схема пала крахом.
Новость сегодняшнего дня, освященная порталом https://www.penzainform.ru/news/crime/2025/12/08/dvoe_penzentcev_poteryali_7_mln_doverivshis_podborshiku_mashin.html Двое граждан лишились 7 млн.
ЦБ РФ обяжет банки привязывать счета россиян к ИНН
Центробанк планирует всерьез взяться за наши банковские счета: хотят обязать ...
Вице-премьер Мантуров: Россия может принять неограниченное число специалистов из Индии. Мы счастливы?
В виду катастрофической нехватки в России трудовых ресурсов, братская Индия ...
00:26
Сколько будем платить за свет в 2026 году: ФАС России пересмотрела тарифы
Сколько будем платить за свет в 2026 году. ФАС России пересмотрела тарифы, рост уже с 1 января нового года
Эпидемия ушлых бабок в России
Россию захлебнула эпидемия "предприимчивых" старух, которые быстро просекли правила игры и пытаются отжать обратно не только квартиры, но и машины, и даже арендованное у них жилье. Казалось бы,...
А, чего, собственно, многие боятся Макса?
Недавно в интернете появился мессенджер МАКС — и вокруг него сразу поднялась небывалая шумиха. Я, не раздумывая, зарегистрировался в нём с первых дней запуска. Вскоре от знакомых я услышал тревожные слухи:
О новшествах с 2026 года при учете дохода при подсчете на ежемесячные детские пособия.
О новшествах с 2026 года при учете дохода при подсчете на ежемесячные детские пособия.
01:13
Как витамин D защищает от болезней сердца и рака: наука о солнечном гормоне
Витамин D является уникальным жирорастворимым витамином, который действует в организме как гормон. Он синтезируется в коже под воздействием ультрафиолетовых лучей типа B (UVB) с длиной волны 290–315 нм.
Говорят, что вирус погибнет при активном солнце летнем.